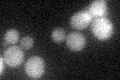
YDL055C
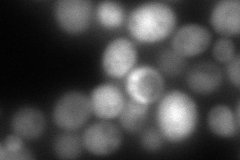
YDL055C
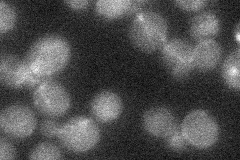
YDL055C
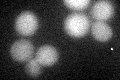
YDL055C
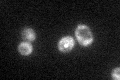
YDL055C

View description
GDP-mannose pyrophosphorylase (mannose-1-phosphate guanyltransferase), synthesizes GDP-mannose from GTP and mannose-1-phosphate in cell wall biosynthesis; required for normal cell wall structure
Localization:
Intensity:
Fold change:
Significance:
-
C’ GFP library in SD
cytosol20.3 -
N' NOP1pr-GFP in SD

cytosol52.6674 -
N' TEF2pr-mCherry in SD
cytosol0 -
N' NATIVEpr-GFP in SD
punctate19.1673 -
N' TEF2pr-VC and Cyto-VN in SD

#N/A0 -
C’ GFP library in SD+DTT
cytosol14.940.73No -
C’ GFP library in SD+H2O2

cytosol17.860.87No -
C’ GFP library in Starvation Media
cytosol25.971.27No -
C’ GFP library on the background of Pup2-DaMP

cytosol -
C’ GFP library on the background of CCT mutant

cytosol18.46450.909367No
